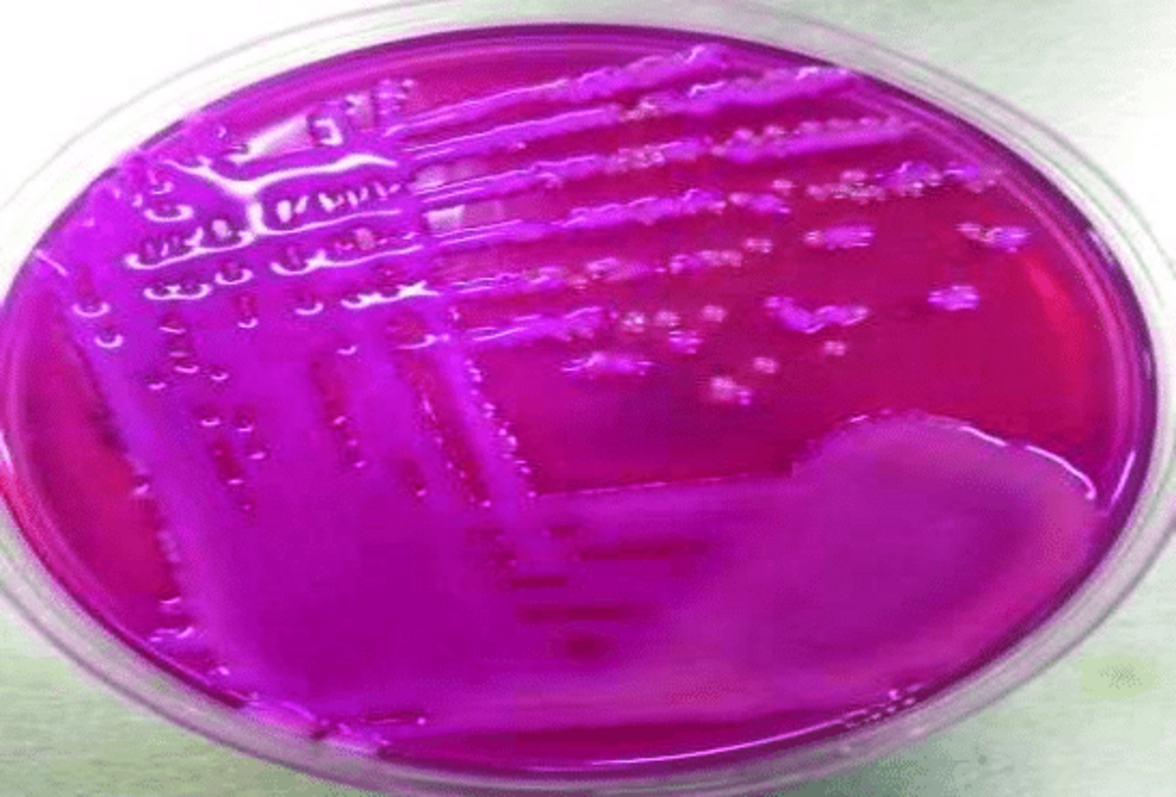
Новый бактериоцин ромсацин из Staphylococcus haemolyticus ингибирует грамположительные патогены

Staphylococcus haemolyticus часто является причиной внутрибольничных инфекций, особенно часто поражая пациентов с ослабленным иммунитетом, имеющих несъемные медицинские устройства.
Клинические изоляты S. haemolyticus часто обладают множественной лекарственной резистентностью и, следовательно, устойчивы к антибиотикам, обычно используемым для лечения стафилококковых инфекций. S. haemolyticus относится к коагулазоотрицательным стафилококкам (CoNS). Близкородственный коагулазоположительный Staphylococcus aureus колонизирует кожу и слизистые оболочки человека и часто является частью нормальной бактериальной флоры. Однако эта бактерия одновременно является одной из наиболее частых причин бактериальных инфекций. Метициллин-резистентный S. aureus (MRSA) и ванкомицин-резистентный S. aureus отнесены Всемирной организацией здравоохранения к глобальным высокоприоритетным патогенам.
Еще одним приоритетным возбудителем является ванкомицин-резистентный Enterococcus faecium (VRE), у которого приобретение генов резистентности к гликопептидам и адаптация к нозокомиальным условиям позволили ему стать успешным оппортунистическим патогеном. Считается, что существующих антибактериальных средств, включая разрабатываемые, недостаточно для решения проблемы растущей антибиотикорезистентности. Перспективной альтернативой или дополнением к антибиотикам являются бактериоцины.
Бактериоцины - это рибосомально синтезируемые антимикробные пептиды, вырабатываемые бактериями и, как правило, убивающие близкородственные виды. Бактериоцины также могут обладать широким спектром действия и часто имеют механизм действия, отличный от антибиотиков. В настоящее время бактериоцины классифицируются в зависимости от наличия или отсутствия посттрансляционных модификаций. Бактериоцины, имеющие посттрансляционные модификации, относятся к классу I, а к классу II - немодифицированные. Для лантибиотиков, относящихся к классу I, характерно наличие тиоэфирных сшивок между цистеином и дегидрированным серином или треонином с образованием необычных аминокислот лантионина и метилантионина, соответственно.
Биосинтез лантипептидов включает дегидратационную и циклизационную модификации пептида-предшественника LanA с последующим протеолизом и экспортом биологически активного бактериоцина Lanα. Кластеры генов лантипептидов кодируют специальные белки для их биосинтеза, в том числе LanM, осуществляющий дегидратацию и циклизацию, и LanTP, удаляющий лидерную последовательность путем протеолитического расщепления и экспортирующий ее во внеклеточное пространство. Традиционно LanA, освобожденный от лидерной последовательности, в немодифицированном виде называют зрелым пептидом, хотя после модификации пептида лидер удаляется.
Продуценты лантибиотиков обладают иммунитетом к собственному бактериоцину за счет продукции белков иммунитета (LanI) и/или белков ABC-транспортеров с функцией иммунитета (LanFE/LanFEG). Некоторые лантибиотики представляют собой двухпептидные бактериоцины, состоящие из Lanα и Lanβ, полученных из пептидов-предшественников LanA1 и LanA2, которые действуют синергично, проявляя максимальную антимикробную активность.
Для поиска бактериоцинов, способных ингибировать S. haemolyticus и родственные виды, клинические и комменсальные изоляты S. haemolyticus (n = 174) были проанализированы на выработку бактериоцинов. Один комменсальный изолят продуцировал антимикробное вещество, ингибирующее S. haemolyticus и Staphylococcus aureus. Вещество обладало физико-химическими свойствами, характерными для бактериоцинов. Очистка, полногеномное секвенирование и масс-спектрометрия позволили идентифицировать антимикробное вещество как новый двухпептидный лантибиотик, названный ромсацином. Бактериоцин проявлял активность в отношении широкого спектра грамположительных бактерий, таких как приоритетные патогены S. aureus [метициллин-резистентный S. aureus (MRSA)] и Enterococcus faecium [ванкомицин-резистентный E. faecium (VRE)]. Важно отметить, что бактериоцин также уничтожал биопленки S. haemolyticus, Staphylococcus epidermidis, MRSA и VRE.
Таким образом, было установлено, что ромсацин является перспективным препаратом для борьбы с антибиотикорезистентными патогенами. Необходимы дальнейшие работы для установления терапевтического потенциала ромсацина, как отдельно, так и в комбинации с другими соединениями, а также для выяснения его структуры и механизма действия.